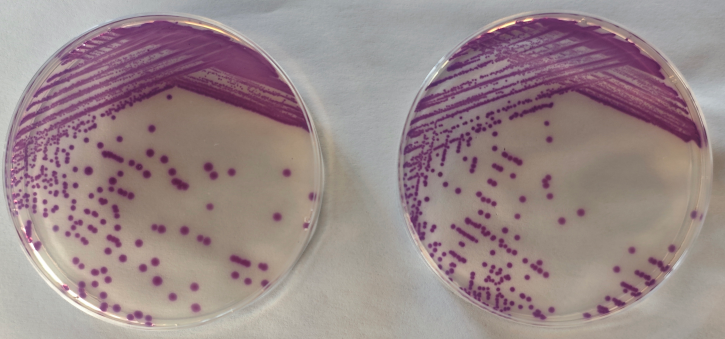

? 2018年����,一次食品中沙門氏菌檢驗(yàn)?zāi)芰︱?yàn)證活動(dòng)����,因?yàn)榭己藰颖局刑砑恿穗p相亞利桑那沙門氏菌�����,多家參與驗(yàn)證的實(shí)驗(yàn)室得到的考核評(píng)價(jià)是“不滿意”。
? ? ??
? ? ? ? 雙相亞利桑那沙門氏菌為何如此特殊?為何會(huì)對(duì)其漏檢呢�?
普通的沙門氏菌顯色培養(yǎng)基
? 大多數(shù)沙門氏菌的乳糖反應(yīng)為陰性��,而雙相亞利桑那沙門氏菌則表現(xiàn)出乳糖陽性和β-半乳糖苷酶陽性��,使得雙相亞利桑那沙門氏菌在普通沙門氏菌顯色培養(yǎng)基上可同時(shí)利用兩種顯色底物�,從而呈現(xiàn)出藍(lán)綠色和紫紅色相互疊加的顏色��,無法準(zhǔn)確呈現(xiàn)目標(biāo)菌的紫紅色�����。
? 我們同時(shí)使用了A���、B����、C三個(gè)品牌的沙門氏菌顯色培養(yǎng)基(根據(jù)說明書,沙門氏菌應(yīng)呈現(xiàn)紫紅色)對(duì)亞利桑那沙門氏菌進(jìn)行了驗(yàn)證��。結(jié)果顯示,各家培養(yǎng)基上的菌落均非紫紅色���,容易導(dǎo)致漏檢。

ATCC 29934腸道沙門氏菌雙相亞利桑那亞種在A B C三個(gè)品牌的沙門氏菌顯色培養(yǎng)基上的菌落形態(tài)
? 同時(shí)也發(fā)現(xiàn)普通的沙門氏菌顯色培養(yǎng)基上,偶爾也會(huì)出現(xiàn)一些干擾菌���,其顏色偏紫紅色��,與目標(biāo)菌相近����,需要做后續(xù)的生化鑒定才能區(qū)分�����。

粘質(zhì)沙雷氏菌(樣品分離菌)在A B C三個(gè)品牌的沙門氏菌顯色上的菌落形態(tài)
盡管我們知道顯色培養(yǎng)基也并非萬能培養(yǎng)基,結(jié)合后續(xù)的生化鑒定可以滿足檢測(cè)的需求��,但我們還是力求能研發(fā)一種更加完美的培養(yǎng)基��,以更好的提高檢測(cè)效率。針對(duì)普通沙門氏菌顯色培養(yǎng)基出現(xiàn)的小瑕疵���,我們研制了新型沙門氏菌顯色培養(yǎng)基—沙門氏+顯色培養(yǎng)基�。
沙門氏+顯色培養(yǎng)基


為了保證培養(yǎng)基的質(zhì)量要求�����,我們將沙門氏+顯色培養(yǎng)基按照GB 4789.28-2024 《食品安全國(guó)家標(biāo)準(zhǔn) 食品微生物學(xué)檢驗(yàn) 培養(yǎng)基和試劑的質(zhì)量要求》附錄F.2中沙門氏菌顯色培養(yǎng)基的質(zhì)控方法對(duì)培養(yǎng)基進(jìn)行驗(yàn)證,結(jié)果符合標(biāo)準(zhǔn)要求����。

GB 4789.28-2024附錄F.2

(左:TSA參比培養(yǎng)基 右:沙門氏+顯色培養(yǎng)基)
CMCC50976 腸炎沙門氏菌腸亞種鼠傷寒血清型PR=0.8

(左:TSA參比培養(yǎng)基 右:沙門氏+顯色培養(yǎng)基)
ATCC14028腸炎沙門氏菌腸亞種鼠傷寒血清型PR=0.75

? 下面我們比對(duì)普通沙門氏菌顯色和沙門氏+顯色培養(yǎng)基的區(qū)別����。
ATCC 14028 腸炎沙門氏菌腸亞種鼠傷寒血清型(左:普通沙門氏菌顯色 右:沙門氏+顯色培養(yǎng)基)

ATCC 29934腸道沙門氏菌雙相亞利桑那亞種(左:普通沙門氏菌顯色 右:沙門氏+顯色培養(yǎng)基)

粘質(zhì)沙雷氏菌(樣品分離菌)(左:普通沙門氏菌顯色 右:沙門氏+顯色培養(yǎng)基)

ATCC 25922大腸埃希氏菌(左:普通沙門氏菌顯色 右:沙門氏+顯色培養(yǎng)基)
通過比較可以看到����,陸橋新產(chǎn)品ESM027沙門氏+顯色培養(yǎng)基在保留了普通沙門氏菌顯色培養(yǎng)基的優(yōu)勢(shì)外��,也完美的解決了其小瑕疵��,包括亞利桑那沙門氏菌可以呈現(xiàn)紫紅色菌落,粘質(zhì)沙雷氏菌呈現(xiàn)非目標(biāo)菌的藍(lán)綠色��,從而提高了效率�,也給檢驗(yàn)員們多一種選擇。
我們也意識(shí)到,隨著對(duì)沙門氏菌研究的不斷深入以及細(xì)菌耐藥性和變異性的持續(xù)發(fā)展�,對(duì)于顯色培養(yǎng)基的研究可能仍需進(jìn)一步深化,以應(yīng)對(duì)未來可能出現(xiàn)的新挑戰(zhàn)�,使其在保障公眾健康方面發(fā)揮更大的作用。